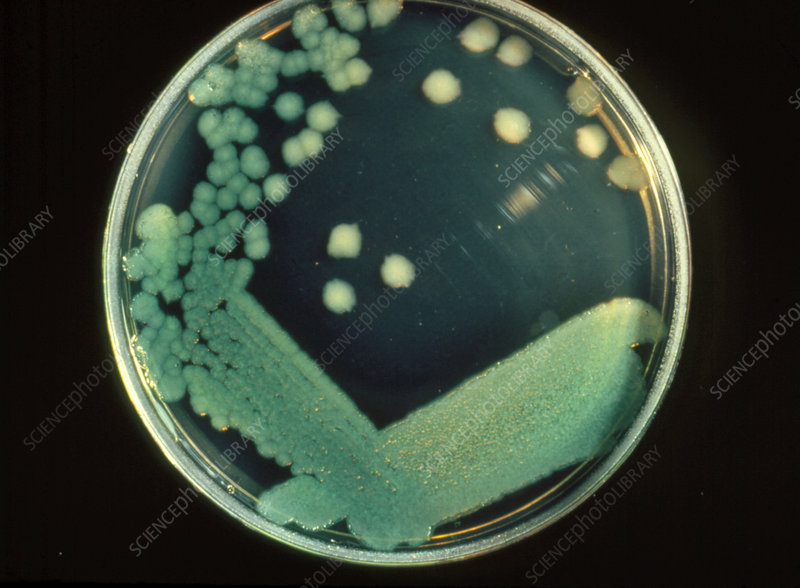
James D Chalmers tweet media

David Connell retweetledi

What about the other pathogens i hear you say?
@alferes_de and @lifearc1 have you covered
Rapid rRNA detection of H. influenzae, S. aureus, S. pneumoniae and M. catarrhalis in bronchiectasis sputum. Better than culture- the future of micro is molecular!
publications.ersnet.org/content/erjor/…
James D Chalmers@ProfJDChalmers
New paper! Collaboration between @EMBARCnetwork and @lifearc1 shows a molecular test can sensitively and accurately detect and quantify Pseudomonas infection in bronchiectasis. The BQA was better than culture @alferes_de @beccahull_ @MereteLong @OSibila publications.ersnet.org/content/erjor/…
English